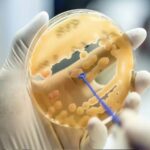
μμμιιικρροοοββιιιοοο

Περιστατικό άσκησης σωματικής βίας σημειώθηκε, λίγο πριν από το μεσημέρι, στο Τμήμα Επειγόντων Περιστατικών του νοσοκομείου Γρεβενών, όταν 33χρονος επιτέθηκε κατά γιατρού που εφημέρευε.
Σύμφωνα με αυτόπτες μάρτυρες, ο άνδρας, που προσήλθε για να εξεταστεί, χτύπησε τον γιατρό επειδή η γνωμάτευση του τελευταίου δεν ικανοποιούσε τις απαιτήσεις του.
Ο 33χρονος συνελήφθη από άνδρες της ΕΛ.ΑΣ. που έφτασαν αμέσως στο σημείο και σε λίγη ώρα θα οδηγηθεί στον Εισαγγελέα Γρεβενών.
Ο γιατρός της Ορθοπεδικής κλινικής νοσηλεύεται με ελαφρά τραύματα στο νοσοκομείο.
protothema.gr

Σημείωση: Τα σχόλια που εμφανίζονται κάτω από τα άρθρα αποτελούν προσωπικές απόψεις των χρηστών που τα δημοσίευσαν και δεν εκφράζουν απαραίτητα τις θέσεις ή απόψεις του Lamianow.gr.
Σε ορισμένες περιπτώσεις, σχόλια που έχουν διατυπωθεί δημόσια σε κοινωνικά δίκτυα ενδέχεται να εμφανίζονται κάτω από τα άρθρα, όταν έχουν δημοσιευθεί κάτω από σχετικές αναρτήσεις του ίδιου άρθρου. Το Lamianow.gr δεν φέρει ευθύνη για το περιεχόμενο αυτών των σχολίων.
Αν κάποιο σχόλιο θεωρείτε ότι παραβιάζει δικαιώματα, είναι προσβλητικό ή έχει αποσυρθεί από την αρχική του πηγή, μπορείτε να επικοινωνήσετε μαζί μας στο [email protected] για την άμεση αφαίρεσή του.